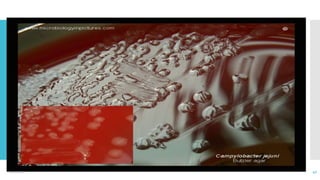
12/2/2021 40

Campylobacter is a genus of bacteria that can cause foodborne illness in humans. The document discusses the history, taxonomy, species, characteristics, habitats, morphology, culture, biochemical reactions, virulence factors, epidemiology, diseases, pathogenesis, clinical symptoms, diagnosis, treatment, and other aspects of Campylobacter. The most common species that causes food poisoning in humans is Campylobacter jejuni, which is often found in the intestines of animals. People typically become infected by eating undercooked contaminated food like poultry. The infection may cause diarrhea, abdominal pain, and fever.